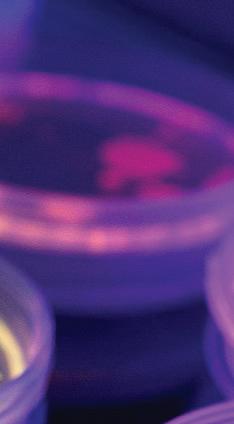

![]()


NH Life Science Members are Meeting the Moment


NH Life Sciences is closing out 2025 with unmistakable momentum. In our second full year, we have doubled our membership, expanded programming, launched new initiatives and raised the profile of New Hampshire’s life sciences sector on both the regional and national stage.

President and CEO
Andrea Hechavarria
This has been an extraordinary year for NHLS. We started our organization with two members, and now we are more than 50. We’re rolling out new programming, engaging in more events and unifying our membership across the state.
NHLS made a significant national impression this summer at the 2025 BIO International Convention in Boston, where New Hampshire’s life sciences companies, educators and innovators were spotlighted on a global platform. We coordinated the state’s presence, convening conversations on workforce development, entrepreneurship and the advantages of growing a biotech company in New Hampshire. NHLS co-founders Cindy Conde, John Whelan and I used the platform to connect with federal officials, international delegations and global biotech firms, further solidifying New Hampshire’s position as a rising hub.
Throughout the year, NHLS continued to expand its programming and member offerings. The NHLS Edge preferred partner purchasing program, which provides discounts on essential lab and business supplies, added
Mike Ambrogi - Senior Technology Fellow, Novocure
new partners and saw increased participation. Members utilizing the program saved $1.1 million this year.
Regular member meetups, policy discussions and facility tours strengthened relationships across the state’s research, manufacturing and education sectors. We added a new event, Empower Life Sciences, which highlighted support for startups and the Seacoast life sciences hub.
The association’s Industry and Education Consortium (IEC) also made major strides, advancing partnerships with K–12 schools, higher education institutions and workforce development organizations. Their work ensures New Hampshire companies can access the skilled talent they need to grow.
The year culminated with the 2nd Annual Live Free Life Sciences Event, where 230 guests joined us to celebrate growth, hear from industry leaders and gain insights from experts, including Anna Puglisi, former director for technology and national security at the White House, and NH Gov. Kelly Ayotte.
“Here in New Hampshire, you are proving that leadership and life sciences don’t depend on being in Silicon Valley or Cambridge,” Puglisi said at the event. “It depends on vision and the ability to connect universities, startups, investors and policy networks into a resilient innovation community.”
The growth of our life sciences community is unmistakable. As we head into 2026, we’re looking to build more partnerships, offer more resources and provide opportunities that foster connection, and ultimately support your growth and innovation in the Granite State. We’re looking forward to it!
Live Free Life Science, Andrea
Steven Kelly - CEO, Timberline Construction and Tenney Mountain Resort
Ryan Holder - Executive Director Operations, Lonza
Matt Simon - Executive Director, UNH Biotechnology Innovation Center & ReGen Valley Common Campus
Kristian Toubourg - Corporate Vice President, Novo Nordisk
Stephanie Grandbois - North America Head of Strategic Partners and Sponsorships, MilliporeSigma
Shelley Briggs - President, BioSummit Strategies, LLC

The rapid growth of life sciences businesses is launching New Hampshire into the future.

Rugged mountains, pristine lakes, vast forests and an Atlantic shoreline have long been iconic images of New Hampshire. But today it could also be gleaming labs, state-of-the-art manufacturing lines and researchers in safety goggles. The rapid growth of life sciences businesses is launching the state into the future, enhancing other industries and drawing attention on a global scale.
NH Life Sciences (NHLS) is a statewide association incorporated in late 2023.
“NHLS was formed to connect and convene the industry to facilitate its broader advancement across the state,” said Andrea Hechavarria, president and CEO of NH Life Sciences. “As a newly formed association, our members have the unique ability to help guide the direction of New Hampshire’s life sciences growth.”
A New Hampshire Department of Business and Economic Affairs report in 2023 spurred leaders into action to form the association. At that point, about 600 New Hampshire life sciences companies were responsible for $4.8 billion in sales and contributed $2.8 billion to the state’s
gross domestic product (GDP). The industry has continued to grow. BIO, the world’s largest biotechnology advocacy association, released a report this past December 2024 noting, “with rapid employment growth of 27.9 percent since 2019, New Hampshire’s bioscience industry has grown significantly faster than the nation.”
Life sciences in New Hampshire have gone from a handful of unaffiliated companies to a priority sector for the state. Clusters of companies have grown around regions with access to higher education institutions and major health systems.
“Over the last 30 years or more, it’s been quite an evolution,” said Mike Ambrogi, senior technology fellow at Novocure and a former general manager for DEKA R&D.
Novocure, an oncology device company based in Portsmouth, is among the NHLS members part of a cluster that’s formed on the Seacoast. Lonza, Pirouette Pharma, OVIK Health are other members working on healthcare innovations. UNH Durham is nearby, where nursing, engineering, biomedical science and other science fields are
among the most popular degrees.
Other clusters include the Interstate-93 corridor between Manchester and Nashua, which was recognized as one of 30 federal tech hubs. The ReGen Valley Tech Hub is led by the Advanced Regenerative Manufacturing Institute (ARMI). Its headquarters in the Manchester Millyard are close to NHLS members UNH Manchester and Elliot Hospital. Within that corridor are NHLS member companies like KeySpin Manufacturing, Sequence Biotech, Foxx Life Sciences, BA Sciences, Resonectics, 3X Genetics, DECCO, and SkyTerra.
MilliporeSigma advances life sciences globally from the Monadnock region, with neighbors like Moore Nanotechnology Systems, Lehnen Lab, Keene State College and Franklin Pierce University.
In the Upper Valley, proximity to Dartmouth Health and Dartmouth College fuels labs working on innovative medical advances by members like Novo Nordisk, BioMT and Caldera Medical.
Steven Kelly is CEO of Timberline Construction, Timberline Communications and Tenney Mountain Resort, three companies that surprisingly all play a role in the life sciences in New Hampshire.
Continued on page 4
“The bigger picture of that master plan isn’t around just the skiing, it’s building the amenities around the skiing,” Kelly said. “It’s really focused on job creation and housing. And the job creation is going to include a heavy concentration in the science and tech — life science industries.”
Plymouth also has access to Plymouth State University, a hospital and a small airport.
“There’s a lot of infrastructure there that allows Plymouth to be ready for this type of growth,” Kelly said.
Boston-Cambridge proximity fueled early growth, but New Hampshire’s business-friendly policies and space for growth have solidified its position as a distinctive option.
“We know that corridor is expanding outside of Cambridge within the life sciences,” Hechavarria said. “Right across the border, we can make it really easy and accessible for a company that is in Massachusetts and is thinking about expanding to New Hampshire, so that they know the industry is unified here and there’s growing interest.”
Thomas Taylor founded Foxx Life Sciences in 2008 out of his home in southern New Hampshire.
“I have traveled to 98 countries and 49 states, New Hampshire is still my favorite place in the world,” Taylor said. “Lakes, mountains, ocean, no sales tax, Boston nearby and quality of life.”
That decision seems to have been a good one for Foxx, which has grown 40% per year for 12 of the past 15 years. The company played a key role in helping the state with COVID test kits and supplying vaccine manufacturers with the materials they needed to scale.
“New Hampshire’s location to higher education, talented people, its businessfriendly environment, and excellent quality of life, make it an ideal location for any life science business,” Taylor said.
New Hampshire’s state government has long tried to create a business-friendly environment. The state was ranked #6 in the Tax Foundation’s 2025 Tax Competitiveness Index of all U.S. states.
Another advantage the state has over
places like Cambridge is open land for new facilities. Renovating existing spaces into R&D laboratories can be costprohibitive compared to building a new facility from the ground up.
“I have a very positive outlook on what New Hampshire can become,” Ambrogi said. “I think that we’ll be able to differentiate ourselves quite well in the next five years.”
“I have traveled to 98 countries and 49 states, New Hampshire is still my favorite place in the world. Lakes, mountains, ocean, no sales tax, Boston nearby and quality of life.”
— Thomas Taylor
Part of NHLS’s work in supporting the life sciences industry is advocating for policies that will help its member businesses grow. Among the most pressing issues that life science executives identified were workforce development and research funding support.
“It’s a big issue: We recruit people here, and we have this nice building right downtown. They can’t live in Portsmouth. Most of our employees can’t afford it,” Ambrogi said. “We’ve been trying to be active, as active as we can be in the affordable housing area. I think it’s important for companies to show up and voice these concerns so that legislators will understand the importance of that.”
Workers are attracted to New Hampshire’s recreational opportunities, positive company cultures and competitive wages (they have the top
industry average salary in the state at $130,850). However, housing availability is a problem for those looking to relocate
A limited venture capital pool in the state can also make it challenging for post-grads to get R&D incubators launched and running. Research grants, expanding the R&D tax credit and growing venture capital in New Hampshire are some ways to support labs that need funding to turn their ideas into discoveries.
“I think there is an opportunity to bring a little more visibility to the innovation side of what’s going on in New Hampshire,” Ambrogi said. “There’s not a strong venture capital presence in New Hampshire for life science. It’s very strong in the Boston area. I’d love to see something more along the lines of a larger venture capital ecosystem.”
For all these challenges, having an association like NHLS gives companies a voice at the State House and a coordinator to arrange collaborative partnerships key to addressing barriers.
“State leaders need to understand the importance of listening to the private sector, who are trying to future-proof their businesses,” Kelly said. “By bringing these companies all together, we’re going to have a combined voice that can start to influence how things are done at the state level.”
By simply working to promote the industry as a whole, NHLS is showing that there is a culture in the Granite State that supports life sciences, which can attract greater expansion.
“We really want New Hampshire to be recognized as a place for life science development,” Ambrogi said. “The trade association is important for supporting the industry and promoting the industry, because I do think that with that attention, that ecosystem will grow, and we’ll have an easier opportunity to recruit.”
Networking events are planned to bring together industry leaders, who can find new ways to support each other, creating an environment for collaboration and not competition.
Novo Nordisk US Bio Production, Inc., in West Lebanon, New Hampshire, expands the Novo Nordisk manufacturing capacity for biopharmaceutical products. As part of the global product supply network, overseen from our company’s headquarters in Denmark, the site’s purpose is to meet current and future demand for our rare disease products. Operators and technicians work various shifts around-the-clock depending on facility and production needs.
A part of the Upper Valley community since 2014, Novo Nordisk’s current facilities include a footprint of 215,000 square feet on 16.2 acres. The site hosts specialized and skilled employees and is a valuable asset in the Novo Nordisk manufacturing portfolio.
Currently, our focus is on the manufacturing of hemophilia and growth hormone disorder products. As part of Novo Nordisk’s long-term plan, the facility in the future may produce other new biopharmaceutical ingredients from Novo Nordisk’s development portfolio.

At Novo Nordisk, we are working to eliminate the environmental footprint from our operations and drive a circular transition across the company to achieve our zero environmental impact ambition. In 2022, this site achieved a key milestone in the Circular for Zero initiative by transferring to Renewable Natural Gas (RNG) as one of our sources of energy.
We are parents, colleagues, neighbors, and friends—people living with the complexities of serious diseases. And we believe in the combination of science and soul to bring better health outcomes to those living with rare chronic conditions. We live this mission at Novo Nordisk every day to benefit patients, their families, as well as the broader community.Novo Nordisk has a strong tradition of generously giving of its time, talent, and financial support in the local community and is committed to making a difference in the Upper Valley through support for local organizations and by providing life-changing careers with competitive benefits to our employees.

LOCATION ESTABLISHED 2014
350 EMPLOYEES
SITE MILESTONES
In 2018 & 2019, the U.S. Food and Drug Administration (FDA) approved two medicines produced at the facility for the treatment of adults and children with hemophilia A.
In 2020, the FDA approved the growth hormone disorder medicine produced at the facility for the treatment of growth hormone deficiency.
In 2022 Site NH swapped from Propane to Renewable Natural Gas (RNG) and is now approximately 98% powered by renewable energy.
SITE AWARDS
Business NH Magazine – Best Place to Work since 2016–2018; – BPW Hall of Fame 2020–2021
215,000 square feet manufacturing facilities located on a 16-acre lot

24/7 OPERATIONS
New Hampshire Location 9 Technology Drive West Lebanon, NH 03784
for
than
This
has given us experience and capabilities that also enable us to drive change to help people defeat other serious chronic diseases such as obesity and rare blood and endocrine disorders. We remain steadfast in our conviction that the formula for lasting success is to stay focused, think longterm, and do business in a financially, socially, and environmentally responsible way. With U.S. headquarters in New Jersey and commercial, production and research facilities in seven states plus Washington DC, Novo Nordisk employs approximately 8,000 people throughout the country. For more information, visit novonordisk-us.com, Facebook, Instagram, and X.
At
the center of NHLS workforce strategy is a network where students, startups and employers converge



With an expected need for additional life sciences employees, NH Life Sciences (NHLS) and its members are working diligently to connect the education pipeline. Providing resources and training to anyone interested in the life sciences will be critical to creating a skilled workforce.
With neighbors such as DEKA, United Therapeutics and the Advanced Regenerative Manufacturing Institute (ARMI) in the Manchester Millyard, the University of New Hampshire at Manchester is uniquely positioned to connect education and industry in biotechnology and life sciences.
In 2019, UNH Manchester opened the Biotechnology Innovation Center (BIC) at its campus in the Millyard. The 18,500-square-foot facility features advanced wet lab space equipped with common equipment for R&D in biotechnology, medical technology, biopharmaceuticals, regenerative manufacturing, and more.
Matt Simon, executive director of the UNH BIC and the ReGen Valley Common Campus and an NHLS board member, explained that the space serves four constituents: early-stage
companies in need of incubator space, faculty researchers, students accessing industry-quality equipment and industry professionals seeking ongoing skills training.
Also operating out of the space is a Small Business Development Center, which offers guidance to startup companies; Manchester Creates, an initiative that provides STEM-related education resources; and the STEM-MoBILE, a traveling lab that brings science to K-12 students across the state.
The BIC is also a hub for the ReGen Valley Common Campus, funded through a $10 million U.S. Department of Commerce – Economic Development Administration grant, as part of the broader $44 million ReGen Valley Tech Hub grant.
The Common Campus is designed to align education with industry needs and develop inclusive educational pathways for students and workers. Currently, nine colleges are part of the program. The Common Campus will allow students to take courses at partner schools.
Manchester Community College (MCC) plays a critical role in the Common Campus, receiving nearly half of this funding to expand their biotechnology and automated manufacturing programs and to create the Center for Biofabrication and
Automated Manufacturing, a training hub for the region.
The biofabrication industry is going to require a robust workforce and there are challenges ahead, Simon said. “There are going to be some pretty significant job gaps. Some are going to require a bachelor’s degree, a master’s degree, a Ph.D. or a postdoc. Others require micro-credentials and certificates.”
The Common Campus will also provide individualized assistance to potential students to find the school in the Common Campus that best meets their needs, plus support, so they can best complete their studies.
With the expansion of life sciences, the demand for staff keeps accelerating. Sparking interest and providing a clear

ensure that our talent pool is equipped to meet the evolving needs of the life sciences industry,” said John Whelan, NHLS co-founder and managing director at Alexander Technology Group, who will be leading the IEC on behalf of NHLS.
In many ways, educational institutions and companies are already addressing life sciences training and workforce development issues.
P&H Electric runs a successful training program – P&H University – that provides an electrical apprenticeship specialized for life science facility work. BA Sciences sources about 60% of its workforce from graduates of the University of New Hampshire and other Granite State colleges, President James Mich said earlier this year.
Lonza is supporting educational initiatives at UNH and Great

pipeline to a career will be key to maintaining and attracting students to the scientific studies and related careers that life sciences will need.
After completing high school, 58% of New Hampshire students who attend a four-year college leave the state (the highest rate in the country). Fewer than half of UNH students work in the state after graduation. Getting more to stay is a goal of NHLS and state partners.
“NHLS is doing a really good job … to really shout the value proposition of being here,” Simon said. “The quality of your life here is incredible.”
Simon highlighted accessibility to recreational opportunities, urban environments, high-quality K-12 schools and higher ed institutions, and business-friendly tax structures.
This spring, NHLS launched an Industry and Education Consortium (IEC) committee.
“This committee will serve as a collaborative platform for industry professionals, educators and stakeholders to enhance workforce development initiatives across New Hampshire and

“We have great partnerships with a number of educational institutions in the New Hampshire area, probably the premier relationship we have, and the most productive, has been with the University of New Hampshire,” said Kevin Kerls, executive site director of Lonza Portsmouth. “The University of New Hampshire is a top-tier research university and is a fantastic resource for the type of work that we do. We found that some of our most dedicated and productive employees come from the University of New Hampshire.”
NHLS aims to build greater coordination between programs like these. “NHLS serves me as a connector,” Simon said. “There are so many different organizations that are all pulling in the same direction, but they’re all pulling different ropes connected to different things. Can we make some connections so that we’re all pulling the same thing together?”
For New Hampshire to scale its life sciences workforce, it’s going to take a convergence of educational pathways to life sciences careers. NHLS helps weave them together.

When the COVID-19 pandemic disrupted everyday life globally, it exposed the fragility of long-distance supply chains. Reshoring medical manufacturing has been a priority since.
“We’ve seen the total life cycle. … A lot of these major manufacturers said: ‘It’s too expensive to manufacture here in America. Let’s do it overseas.’ But they still kept an R&D footprint here. We’ve now seen (manufacturing) come back,” said Kyle Reagan, president of DECCO, which specializes in biotech and industrial construction, maintenance and critical equipment handling. “We’ve seen manufacturing come back in spades.”
The synergy of life sciences and advanced manufacturing has never been more important. In New Hampshire, manufacturing infrastructure is allowing life sciences companies to innovate, reduce risks and improve speed to market, all while strengthening the state’s economy and providing workers with better-than-living wages.
New Hampshire’s economy has long been fueled by manufacturing, with hydropowered mills turning wood pulp into paper and cotton into cloth. While that spirit of hard work, innovation and industry remains, today’s manufacturing looks very different.
“We started in 2001 and we design and build manufacturing machinery for life sciences and other industries,” said Peter Lehnen, president and lead designer at Lehnen Labs. “The life science industry has unique requirements for machinery.”
Lehnen’s work is a few steps removed from the research and development of medicines and other biotech products, but it provides a foundational service to companies looking to produce innovations at scale.
“Life sciences incorporates so many things, from medical devices to pharmaceuticals and all the vertical components that go into making those,” Lehnen said. “We don’t directly make equipment for making pharmaceuticals; for example, we build the machinery that builds the devices that are then
consumed by the pharmaceutical manufacturers.”
Much of the work behind the designs Lehnen Lab makes for other companies is covered by non-disclosure agreements. However, it was able to share that fellow NH Life Sciences member MilliporeSigma hired them to design a fully automated and programmable tubing cutter that could be adjusted for various diameter tubes. Lehnen’s device can complete upwards of 10,000 cuts without replacing the blade.
There can be a lot of back and forth with machine designers and manufacturers to get the process just right. Being close to clients who will use your machines can help facilitate more in-person development during the process.
“We’re so close to the Boston life sciences corridor, so we’re considered very local,” Lehnen said. “There’s not a lot of the kind of resources we provide in the area. … NH Life Sciences can promote that this type of capability exists in the state and that people don’t have to go far to get first-class support for their manufacturing processes.”
Page left: Members of the Greater Monadnock community tour Lehnen Lab, a 1,600-squarefoot state-of-the-art proof-ofconcept lab, which opened last fall in Keene. Right: Resonetics in Nashua is a global leader in medtech micro-manufacturing.


Over nearly four decades, Resonetics, a Nashua contract design and manufacturing organization (CDMO), has grown to 17 facilities globally.
“What we do is we help our customers design, manufacture and scale novel medical technology,” said Keven Kelly, president of Resonetics.
“In the next three years, we’re looking to grow 50%. We have a plan to grow to $1 billion in sales.”
Kelly said that access to customers is one of the challenges the company faces. It has mitigated that challenge by operating sites nearby, while keeping a central headquarters in the Granite State.
“I think people overlook it, but we have proximity to Europe,” Kelly said. “There are a lot of decisions being made in Europe, particularly in Ireland.”
New Hampshire’s tax policy, ample facility capacity, proximity to transportation from Manchester and Logan airports, and the overall vibrancy of life sciences in New Hampshire make the location attractive.
However, access to talent is particularly important to Resonetics during its growth efforts. Kelly said the company never struggles to hire workers for its Nashua location.
“All the functions – whether it be finance, IT, quality, supply chain, operations, engineering – we have to recruit those roles, and we can find talent
in this area,” Kelly said. “So that’s number one, because I have to tell you, if I go out to California and try to do that, it’s very hard, very competitive.”
Other benefits of locating life sciences manufacturing in the United States, including New Hampshire, include avoiding increasing tariffs on overseas products, shorter lead time in getting products to a U.S. market and proximity to regulatory agencies that can help streamline the FDA approval process. These qualities can remove some of the unpredictability from the production cycle. When Granite State companies need supplies or expertise to create life-saving products, help is here, close to home and ready to grow.
MilliporeSigma is the U.S. and Canada Life Science business of Merck KGaA, Darmstadt, Germany.

Amherst
• Elliott Controls
• Sequence Biotech
Bedford
• Suntra
• Sullivan Construction
Concord
• The Business and Industry Association of NH
• The Community College System of NH
Durham
• The University of New Hampshire
• Trellis Labs
Jaffrey
• MilliporeSigma
Keene
• Electronic Imaging Materials
• Hannah Grimes Center for Entrepreneurship
• Lehnen Lab
Lebanon
• Adimab
• BioMT
• BIO X Cell
• Celdara Medical
• Mascoma (Lallemand)
• Novo Nordisk

Londonderry
• Agora
• Foxx Life Sciences
Manchester
• Elliot Health System
• Faraday Bio
• 3X Genetics
Merrimack
• KeySpin
• HiArc
• Timberline Construction and Communications
Nashua
• DECCO
• Predictive Monitor
• Resonetics
• SkyTerra
Plaistow
• P&H Electric
Plymouth
• Plymouth State University
• Tenney Mountain
Portsmouth
• Lonza
• Mintz
• Novocure
• Ovik Health
• Pirouette Pharma
• Portsmouth Collaborative
• Tenovi
Rollinsford
• Arnion Bio
Salem
• Alpco
• BA Sciences
• Pace Life Sciences
Warner
• MadgeTech
Maine
• BBI Solutions Portland
Massachusetts
• Hodess Clean Rooms Attleboro
• Safety Partners Bedford
• Park Street Strategies Boston
• Middlesex Gases Everett
• Ethikos Tech Tewksbury


MEMBERS









Faraday Bio





ASSOCIATE MEMBERS






PROUD PARTNERS

































Anyone who has been paying attention to the evolution of New Hampshire’s life sciences sector will have noticed something: The state is making a name for itself as a distinctive cluster of innovative biotech startups, global pharmaceutical companies, medical device manufacturers, educational institutions and service providers, such as engineers, builders and safety consultants, who specialize in the industry.
Fueling this evolution and linking these organizations is New Hampshire Life Sciences (NHLS), the industry association that’s weaving together the threads into a cohesive and influential life sciences community.
Companies that want to have a voice in this industry shouldn’t be asking, “Why should I join NHLS?” The question is “Why wait?”
“I try to make myself available to go to as many of NHLS’s events as possible, because you never know who you’re going to meet,” says Conor Cullinane, CEO of Pirouette Pharma. “You never know what value we can bring, but at the same time, what the folks that we’re going to meet ultimately are meaningful for our growth.”
From casual industry roundtables and CEO-to-CEO discussions to highvisibility events like the Empower Life Sciences Showcase and Live Free Life
Sciences, NHLS creates strategic relationships between innovators, officials and skilled service providers.
NHLS doesn’t just host events; it facilitates learning opportunities. When U.S. Rep. Maggie Goodlander wanted to learn more about the state’s life sciences, NHLS arranged a tour of BA Sciences in Salem. Goodlander heard directly from company leadership and lab workers on what is being developed in the state, the benefits of the industry and the support that would enhance their work.
For Steven Kelly, CEO of Timberline, NHLS offers something particularly valuable to companies that support the industry: a unified voice at the State House.
While some life sciences companies are growing well on their own, future expansion will require state support for infrastructure upgrades, higher education funding and business incentives.
NHLS regularly coordinates highlevel engagement between policymakers and the companies shaping the industry that is of strategic importance to New Hampshire.
NHLS educates lawmakers about the complex needs of life science companies and provides a forum for members to directly engage with elected leaders. In recent months, members have participated in Legislative Day events, CEO dinners and one-on-one meetings with leadership, including Gov. Kelly Ayotte.
Not every NHLS member is a scientist in the lab. Associate members such as data engineers, construction specialists, safety consultants and materials suppliers have joined to stay in tune with what’s happening across the ecosystem.
NHLS provides insight into what companies are moving to New Hampshire, which development projects are ramping up, and who’s influencing pharma, biotech, and diagnostics. Associate members gain access to the same events and visibility tools, from newsletter highlights to online profiles, allowing them to build credibility and support clients with up-to-date industry knowledge.
Mike Ambrogi of Novocure, one of the state’s leading life sciences companies, emphasizes a key benefit of NHLS: creating a self-sustaining ecosystem.
“We really want New Hampshire to be recognized as a place for life science development and for life science companies to thrive,” Ambrogi says. “It’s important to us to be in that ecosystem.”
For startups and smaller companies, especially, the organization is a critical support. Through NHLS, members can connect with advisors, access peer learning opportunities, join workforce development pipelines and tap into savings programs that help them grow more efficiently.
New Hampshire’s life sciences companies range from two-person startups to global medical device manufacturers. What they have in common is a need for supplies, business tools and cost savings.
NHLS formed a strategic partnership with MassBio that gives its members access to significant operational cost savings on critical goods and services. Included with membership is access to the NHLSEdge program, which aggregates the collective buying power of MassBio and NHLS members to offer significant discounts, favorable terms and enhanced customer services with participating vendors.
In 2025, the 10 members who used the NHLS Edge program saw $1.1 million in savings.
Vendors in the network cover everything from HR solutions, lab equipment, employee rewards experiences, subscriptions and shipping.
“The money that a biotech company or life science company can save by joining NHLS and participating in the Edge program would actually pay for their membership at NHLS, and they’d still be saving more money,” says Steve Kelly, CEO of Timberline Construction Corp.
NHLS Edge boasts an impressive roster of “preferred partners,” including Fisher Scientific, Veolia Environmental Services, Middlesex Gases and W.B. Mason.
With less money spent on the same materials, New Hampshire’s businesses working in the life sciences industry can focus their resources on innovating and R&D, to bring that next potential cure or technology to market.
Having the preferred partners program also means that entrepreneurs just getting the business off the ground know that they are working with vetted vendors who have experience with the life science industry. This can streamline the process and help save time as well as money.






On Nov. 12, NH Life Sciences (NHLS) celebrated its second annual Live Free Life Sciences showcase. The speakers and panelists reinforced that New Hampshire’s small size is its strength, with low business taxes, nimble get-it-done policy-making, and a web of resources addressing challenges from workforce development to rising materials costs.
More than 250 guests at the event in Salem heard from Anna Puglisi, former director for technology and national security at the White House; Gov. Kelly Ayotte; Dr. Jennifer MacDonald, COO of the Advanced Regenerative Manufacturing Institute (ARMI); and eight industry expert panelists.
“Here in New Hampshire, you are proving that leadership and life sciences don’t depend on being in Silicon Valley or Cambridge,” Puglisi said. “It depends on vision, the ability to connect universities, startups, investors and policy networks into a resilient innovation community. Your companies and research institutes are building that network in regenerative


READ WHAT OTHERS ARE SAYING ABOUT LIVE FREE LIFE SCIENCES IN THE CONCORD MONITOR

medicine, advanced materials and biomanufacturing.”
NHLS doubled its membership in 2025 to more than 50 organizations. By joining the industry trade group, the collective can better promote existing resources for life sciences, while building programs to address gaps.
“I think back 10 years ago, we had a patchwork of programs,” said workforce development panelist Matt Simon, executive director of the UNH Biotechnology Innovation Center. “We don’t have a patchwork of programs now. We have a network. We have an ecosystem. It’s here.”
From research-stage startups to global enterprises, there is something in New Hampshire for every company, and NHLS is here to connect you with those benefits. Speakers throughout the evening highlighted the missiondriven motto of NHLS: “Start here. Grow here. Make a difference here.”
“New Hampshire is a state that values freedom,” Ayotte said. “We value innovation, we value new ideas, and we very much value you. New Hampshire is the place where you have the freedom to take risks and to make sure that you have the resources needed to grow your company.”





Together with our patients, we strive to extend survival in some of the most aggressive forms of cancer by developing and commercializing our innovative therapy.
FEBRUARY: LEGISLATIVE DAY
MARCH: C-LEVEL DINNER

WAPRIL: MEDTECH EVENT
SEPTEMBER: EMPOWER LIFE SCIENCES
NOVEMBER: LIVE FREE
YEAR-ROUND
QUARTERLY: SPOTLIGHT RECEPTIONS
BI-MONTHLY: WEBINARS
ith a panoramic mural of the White Mountains and an inviting emerald couch, NH Life Sciences’ booth at BIO International 2025 reflected the state itself: grounded, welcoming and full of possibility. Over four days, NHLS leadership and partners showcased why New Hampshire deserves its place among 20,000 global biotechnology leaders.
As a first-time exhibitor, NHLS delivered a clear message: New Hampshire is ready to compete on the global stage, offering both the infrastructure to scale from R&D to manufacturing and a quality of life that helps companies thrive. The booth was supported by Fisher Scientific, the University of New Hampshire, Predictive Monitor, BEA, PCI Pharma, Lehnen Lab, and Pirouette Pharma, with additional participation from members, including Safety Partners and Predictive Monitor. Conversations centered on a single question: What is New Hampshire’s value proposition? As co-founder Cindy Conde noted, the answer is now being shared by a rapidly expanding network.
New Hampshire offers space, resources, and an attractive lifestyle for companies ready to scale. While the state supports the full ecosystem—from


R&D incubators to manufacturing—its sweet spot is helping companies move into production. Lower taxes, business incentives, and available facility space offer a cost-effective alternative to crowded nearby hubs like Boston–Cambridge. The state’s recreational and cultural amenities help companies recruit and retain talent, while colleges and universities continue building strong workforce pipelines.
Then BEA Commissioner Taylor Caswell said the state’s sponsorship of the booth reflects that New Hampshire is “worthy of being in the global biotech conversation.”
For NHLS President Andrea Hechavarria, NHLS’s first appearance at BIO was both energizing and validating. “From the booth location…to witnessing the energy and passion from those in the industry, it was a great success,” she said. The convention also offered a perspective on global investment trends, collaboration, and scientific breakthroughs. NHLS met with neighboring hubs, international partners, and members with existing New Hampshire footprints, including Lonza and MilliporeSigma.
For NHLS co-founder John Whelan, BIO marked a milestone: “There was a substantial amount of interest and energy around life sciences growth in New Hampshire.”






NH Life Sciences launched its inaugural Empower Life Sciences showcase in September, bringing together industry leaders, startup founders and community partners. Through two dynamic panel discussions and networking opportunities, attendees explored how global companies, local talent and a strong entrepreneurial ecosystem are reshaping the region.
Portsmouth Mayor Deaglan McEachern kicked off the event by reflecting on the city’s evolution, from economic uncertainty following the closure of Pease Air Force Base to today’s thriving mix of biotech giants and homegrown startups. That transformation, he said, is fueling “a remarkable new chapter” for the Seacoast.
Representatives from two of the area’s largest life sciences employers, Novocure and Lonza, joined regional leaders to discuss the impact of their work. Novocure’s Heather Clark highlighted the company’s progress treating glioblastoma, noting it has
served more than 40,000 patients to date. Lonza Portsmouth’s site head, Kevin Kerls, detailed the facility’s key role in manufacturing Moderna’s COVID-19 vaccine and its partnership with Vertex on a groundbreaking stem cell therapy for Type 1 diabetes.
Panelists emphasized that the Seacoast’s strength lies in its people: creative problem solvers with deep roots in the community. Kerls praised the region’s education pipeline, pointing to strong partnerships with Great Bay Community College and UNH that help local talent stay and grow. Collaboration, not competition, he added, is the mindset driving the region forward.
The event’s second panel examined what it takes to navigate today’s challenging venture capital environment. Moderated by Mintz attorney Dean Zioze, the session featured advisors from Gilde Healthcare, Mass General Brigham Ventures, Pirouette Pharma and UNH Innovation. Speakers painted a realistic picture: funding is available, but startups must be data-driven, persistent and prepared.
Pirouette Pharma’s journey—from a student engineering idea to a funded medtech startup—illustrated the importance of belief funding, incubator support and milestone-based investment. UNH Innovation’s Gary Sclar underscored the importance of strong intellectual property and expanding angel networks to help new ideas gain traction.
Across both panels, a clear takeaway emerged: the New Hampshire’s life sciences momentum is building, powered by collaboration, world-class talent and a shared commitment to transforming bold ideas into real-world impact.

Thank you to Mintz for being our 2025 Spark Sponsor
